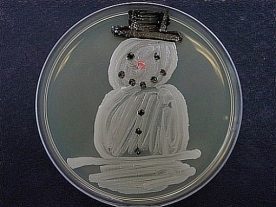
microbiallsnowman

This week we tackle the addition of three subsidiaries of BGI Group (formerly the Beijing Genomics Institute) to the US Entity List, the ongoing discussion regarding DOE’s recent COVID-19 origins assessment, congressional hearings on the same subject, and updates on the suspected poisonings of school girls in Iran. This issue also has several new publications and upcoming events, including one discussing the outcome of Germany’s intervention in a suspected IS-inspired plot using ricin and an upcoming book talk with Dr. Katherine Paris, an alumna of the Biodefense PhD program.
US Department of Commerce Adds Three BGI Subsidiaries to Entity List
Effective March 2, 2023, the US Department of Commerce officially added three subsidiaries of BGI Group, formerly the Beijing Genomics Institute, to the Entity List. The Entity List is published by the Department of Commerce’s Bureau of Industry and Security (BIS) and requires foreign persons, entities, and governments to meet US licensing requirements for export and transfer of certain items. Placement on the list does not prohibit companies and persons in the US from purchasing from or doing business with these entities. About 600 Chinese entities are on the list, including many known to have aided the PLA in creating artificial islands throughout the South China Sea. The Biden administration has added over 110 Chinese entities to the list, in large part because of the PRC’s military-civil fusion policies and the two-way transfers they have facilitated between companies, research institutions, universities, and the People’s Liberation Army (PLA).
The BIS announcement read in part: “The ERC [End-User Review Committee] determined to add BGI Research; BGI Tech Solutions (Hongkong) Co., Ltd.; and Forensic Genomics International, to the Entity List, under the destination of China, pursuant to § 744.11 of the EAR. The addition of these entities is based upon information that indicates their collection and analysis of genetic data poses a significant risk of contributing to monitoring and surveillance by the government of China, which has been utilized in the repression of ethnic minorities in China. Information also indicates that the actions of these entities concerning the collection and analysis of genetic data present a significant risk of diversion to China’s military programs. These entities are added with a license requirement for all items subject to the EAR.”
BGI released a statement in response to the announcement, saying “We believe the BIS’s decision may have been impacted by misinformation and we are willing and able to clarify. BGI Group’s work strictly abides by local, regional, and global moral and ethical standards, and adheres to all required laws and regulations. BGI Group does not condone and would never be involved in any human-rights abuses. None of BGI Group is state-owned or state-controlled, and all of BGI Group’s services and research are provided for civilian and scientific purposes.”
As we discussed early last year, BGI is known to have used its NIFTY test, a prenatal test used globally, to collect data in collaboration with the PLA. Furthermore, early in the pandemic, as the US struggled to build testing capacity and states could not run their own tests in their state labs, BGI Group targeted US state governments with cheap tests that promised to rapidly increase their capacity. The company also worked with the PLA on projects aiming to make ethnic Han Chinese people less susceptible to altitude sickness, though BGI Group claims this work was purely academic in nature. The all adds to growing concerns that foreign entities are using seemingly harmless products, such as at-home DNA tests like 23andMe or AncestryDNA, can be exploited by adversaries.
COVID-19 Origins…Familiar Arguments, Renewed Vitriol
Predictably, discussion of last week’s announcement that the Department of Energy assesses with low confidence that SARS-CoV-2 very likely originated in a laboratory has continued with much fervor this week. This section covers some recent publications discussing this as well as the recent congressional hearing focused on the matter.
Updates on Discussion of DOE and FBI’s Assessments
As we discussed last week, there has been a lot of online discussion of the updated intelligence assessment from DOE that inadequately explains what the Department actually found and what it means. Cheryl Rofer explains in her recent Scientific American piece that 90 day intelligence estimates are not the end-all and be-all, especially in a situation like this. She writes that “An intelligence assessment isn’t a scientific conclusion. They are different beasts. The summary itself observes that different agencies weigh intelligence reporting and scientific publications differently. The important factor for intelligence assessments is the veracity of sources, whereas scientific conclusions depend on data and the coherence of the argument the data support. However, data from a scientist who has proved unreliable in the past will weigh less heavily in scientific conclusions, and intelligence analysts will regard fanciful stories from an otherwise reliable informant skeptically. The scientific data are available to the public, unlike the reporting that underlies the intelligence assessments.”
Rofer also explains how the intelligence divisions of national laboratories work, writing “Cutting-edge science is the expertise of the Department of Energy, however, which runs 17 national laboratories, several studying SARS-CoV-2 and its origins. Intelligence professionals in the national laboratories work with scientists to develop assessments. Because they are embedded in the laboratories, they can develop working relationships to explore puzzles of science and intelligence. Because I was responsible for a similar environmental cleanup site at Los Alamos National Laboratory, a question that I was involved in during the 1990s was whether the Soviets had done hydrodynamic tests at the Semipalatinsk Nuclear Test Site, scattering metallic plutonium chunks. Members of the intelligence division came to me and other chemists, and our physicist colleagues, to learn how and why such tests would have been performed, and what clues they would leave behind for analysts to spot. Eventually, we found that indeed tests were run in this way. A joint program with Russia and Kazakhstan recovered 100 kilograms of plutonium that might have gone to scavengers, as a result of this detective work.”
Furthermore, as Drs. Angela Rasmussen and Saskia Popescu (assistant professor in the Schar School Biodefense Program) explain in their piece for the Washington Post, “No new evidence is available for public scrutiny. It is impossible to evaluate the Energy Department’s claims. Yet they have been repeated in many quarters as if they were proof of a lab origin — a belief that fuels demands to curtail work on dangerous infectious agents…This circus makes the United States and the world less prepared, not more, to defend itself against emerging pathogens that could lead to pandemics, including the alarming influenza strain H5N1 spreading globally in animals or the deadly Marburg virus outbreakin Equatorial Guinea.”
In their piece, Rasmussen and Popescu highlight the critical oversight of the risk that cities where people and animals live in close contact pose. They write “Only in a city with a large, mobile, interactive population of people and animals could the virus establish sustained onward transmission from person to person. This pandemic could have just as easily begun in Beijing, Shanghai or Guangzhou — where SARS-CoV-1 emerged in 2002, also as a direct result of the sale of live animals at “wet markets.”
Promised Congressional Hearings Kick-Off with House Oversight Select Subcommittee on the Coronavirus Pandemic Hearing
Rasmussen and Popescu summarize much of the problems and concerns with the congressional hearing in their piece mentioned previously, writing “Deepening partisanship on covid-19 hinders progress at home and abroad. None of the witnesses called so far by the House Select Subcommittee on the Coronavirus Pandemic for its first hearing this week has technical expertise on SARS-CoV-2 origins science. Few have experience within the covid-19 response effort. All have promoted pro-lab leak opinions without providing any evidence to support their claims. It is easier to place blame than to address systemic issues that led to more than a million covid deaths in the United States.”
The majority’s witnesses included Dr. Jamie Metzl, a historian of Southeast Asia whose career has largely centered on humanitarian policy; Nicholas Wade, a former science editor at the New York Times who drew criticism for his 2014 book that asked, in reference to economic issues in many African countries, whether “variations in their nature, such as their time preference, work ethic and propensity to violence, have some bearing on the economic decisions they make.”; and Dr. Robert Redfield, a physician who was the CDC director during the Trump administration and has ample clinical research experience, largely focused on HIV/AIDS. The minority witness was Dr. Paul Auwaerter, an infectious disease physician whose researcher includes work on Lyme Disease and EBV.
As Jon Cohen explains in Science Insider-“Some scientists and legislators might have hoped this morning’s U.S. congressional hearing on the origin of the COVID-19 pandemic would move beyond partisan politics and seriously investigate what has become a deeply divisive debate. But members of the House of Representatives’ Select Subcommittee on the Coronavirus Pandemic mostly hammered home long-standing Republican or Democratic talking points, shedding no new light on the central question: Did SARS-CoV-2 naturally jump from animals to humans or did the virus somehow leak from a laboratory in Wuhan, China?”
Of course, much of the witness statements and questions focused on the EcoHealth Alliance and its role in projects with the Wuhan Institute of Virology. In response to several of the statements, the EcoHealth Alliance issues these corrections to assertions made at the hearing. Of particular interest is the status of the DEFUSE proposal that was submitted to DARPA, a frequent talking point in online lab-leak discussions. Of this, the Alliance writes plainly “…the proposal was not funded and the work was never done, therefore it cannot have played a role in the origin of COVID-19.”
Bloomberg also published a piece discussing how this drawn out, unproductive discourse obscures the rise globally of high-security biolabs, which features the work of Biodefense Graduate Program Director Dr. Gregory Koblentz and Dr. Filippa Lentzos of King’s College London. Of the politicization this has brought, Dr. Koblentz was quoted saying “Nobody wants lab accidents…Unfortunately this issue has become politicized and polarized. That’s because the people with the loudest voices have had the microphone.”
Iran Poisonings
According to NBC, at least 2,000 people in Iran have reported symptoms since concerns about deliberate poisonings of schoolgirls in the country first emerged, though some members of parliament estimate that number could be as high as 5,000. This comes as videos circulate of young girls coughing profusely as they are escorted out of school, with others showing girls slumped over and struggling to breathe in hospitals. So far, 30 schools in at least 10 provinces have reported cases of girls mysteriously falling ill. This has led to mounting protests in Tehran, which is particularly troubling in light of recent protests over the death of Mahsa (Jina) Amini, a young Kurdish woman, in police custody after she was arrested by the Islamic religious police for allegedly violating modesty standards.
President Ebrahim Raisi spoke out this week about the issue, ordering investigations and telling the cabinet that these incidents are “an inhumane crime” aimed “at intimidating the students, our dear children, and their parents,” according to state media. The supreme leader, Ayatollah Ali Khamene, also said that, if these allegations are confirmed, that they constitute a “great and unforgivable crime” and that “the culprits must face the toughest of punishments.”

“Can a 1975 Bioweapons Ban Handle Today’s Biothreats?”
In this piece for the Bulletin of the Atomic Scientists, Matt Field writes “Rapid advances in biotechnology and the lack of an enforcement mechanism are challenging the Biological Weapons Convention. Amid swirling allegations that countries are violating the treaty, are slow-moving attempts to update it enough to prevent biological doom?” In it, he discusses challenges in adapting the treaty to current issues, quoting Biodefense Graduate Program Director Dr. Gregory Koblentz, writing “It is worrisome that states parties can’t agree on relatively simple propositions that would ensure that the Article 1 prohibition on developing biological weapons includes biological agents produced or modified via emerging technologies such as genome editing,” Koblentz, the George Mason University biosecurity expert, said.”
“Model Law for National Implementation of the 1972 Biological and Toxin Weapons Convention and Related Requirements of UN Security Council Resolution 1540”
New from VERTIC: “This Model Law was developed to assist countries in drafting legislation to implement the 1972 Biological and Toxin Weapons Convention and the biological weapons-related provisions of UN Security Council Resolution 1540.”
“It can be used to identify all the relevant measures that should be included in national legislation to give effect to the BWC and related provisions of UNSCR 1540. It can further be used during the legislative drafting process. As there is no “one size fits all” approach for the drafting of national implementing legislation, each state should determine the type of implementing measures it requires in accordance with its constitutional processes, legal tradition, existing legal framework, activities in the field of bioscience and other national circumstances. The Model Law is therefore intended to provide a useful basis to draft BWC implementing legislation and can be used to draft new legislation, or amend existing laws and/or regulations.”
“Ricin’s Round Two: Germany Prevents Another Islamic State-Motivated Bioterrorism Attack”
Herbet Maack’s piece in the Terrorism Monitor discusses the outcomes of Germany’s January intervention in a suspected IS-inspired attack. Maack writes in his conclusion, “The disrupted plot of Monir J. and Jalal L. shows the continued threat from loosely IS-connected and IS-inspired individuals. It also underscores the continued interest of Islamist-motivated perpetrators in bioterrorism and their desire to inflict significant losses of life. For Germany, the disrupted plot was already the second one involving ricin. While US-German counterterrorism intelligence cooperation seems to be functioning well, the potentially catastrophic consequences for any failure should cause Berlin to consider strengthening its own domestic counter-terrorism intelligence gathering capabilities.”
“Diverse Voices in International Security: NTI’s Gabby Essix on Promoting Diversity, Equity, and Inclusion in the Biosecurity Field”
This interview with Grabby Essix, a Bio Program Officer at the Nuclear Threat Initiative, discusses DEI efforts in the biosecurity field: “NTI is committed to highlighting and supporting diversity, equity, and inclusion (DEI) in the peace and security field. During February, Black History Month, NTI Deputy Vice President for Communications Rachel Staley Grant sat down with NTI | bio Program Officer Gabrielle (Gabby) Essix to discuss DEI efforts in the biosecurity field. Essix supports NTI’s efforts to increase global action on biological and health security through the Global Biosecurity Dialogue and the Global Health Security Index and she leads NTI’s annual Next Generation for Biosecurity Competition. Since 2017, this competition has fostered professional development for rising global leaders in the field of biosecurity and biosafety, and it promotes DEI within the global health security community.”
“Toxic Inheritance: Assessing North Korea’s Chemical Weapons Capability”
This essay from Royal United Services Institute discusses ongoing work using open source research and remote sensing technologies to assess the DPRK’s CW capabilities and production capacity. This essay provides a review of historical documents related to the program and identifies 33 sites of interest in the country, with the promise of creating a map of more sites at a later date with alleged links to CW production.
“Verification of Exposure to Chemical Warfare Agents Through Analysis of Persistent Biomarkers in Plants”
De Bruin-Hoegée et al. discuss the possibility of using plant biomarkers in forensic reconstructions of chemical warfare attacks in their article in Analytical Methods. Abstract: “The continuing threats of military conflicts and terrorism may involve the misuse of chemical weapons. The present study aims to use environmental samples to find evidence of the release of such agents at an incident scene. A novel approach was developed for identifying protein adducts in plants. Basil (Ocimum basilicum), bay laurel leaf (Laurus nobilis) and stinging nettle (Urtica dioica) were exposed to 2.5 to 150 mg m−3 sulfur mustard, 2.5 to 250 mg m−3 sarin, and 0.5 to 25 g m−3 chlorine gas. The vapors of the selected chemicals were generated under controlled conditions in a dedicated set-up. After sample preparation and digestion, the samples were analyzed by liquid chromatography tandem mass spectrometry (LC-MS/MS) and liquid chromatography high resolution tandem mass spectrometry (LC-HRMS/MS), respectively. In the case of chlorine exposure, it was found that 3-chloro- and 3,5-dichlorotyrosine adducts were formed. As a result of sarin exposure, the o-isopropyl methylphosphonic acid adduct to tyrosine could be analyzed, and after sulfur mustard exposure the N1- and N3-HETE-histidine adducts were identified. The lowest vapor exposure levels for which these plant adducts could be detected, were 2.5 mg m−3 for sarin, 50 mg m−3 for chlorine and 12.5 mg m−3 for sulfur mustard. Additionally, protein adducts following a liquid exposure of only 2 nmol Novichock A-234, 0.4 nmol sarin and 0.2 nmol sulfur mustard could still be observed. For both vapor and liquid exposure, the amount of adduct formed increased with the level of exposure. In all cases synthetic reference standards were used for unambiguous identification. The window of opportunity for investigation of agent exposure through the analysis of plant material was found to be remarkably long. Even three months after the actual exposure, the biomarkers could still be detected in the living plants, as well as in dried leaves. An important benefit of the current method is that a relatively simple and generic sample work-up procedure can be applied for all agents studied. In conclusion, the presented work clearly demonstrates the possibility of analyzing chemical warfare agent biomarkers in plants, which is useful for forensic reconstructions, including the investigation into alleged use in conflict areas.”
“Twenty Years Ago in Iraq, Ignoring the Expert Weapons Inspectors Proved To Be a Fatal Mistake”
In this essay for the Stockholm International Peace Research Institute, Robert E. Kelley discusses the US invasion of Iraq in 2003 and faulty claims about Iraqi WMD programs that drove the decision to invade. He writes in part, “I was in Iraq in those final months before the 2003 invasion as Deputy for Analysis of the International Atomic Energy Agency (IAEA) Action Team tasked with the nuclear side of the weapons inspections, while the UN Monitoring, Verification and Inspection Commission (UNMOVIC) worked in parallel, looking for biological and chemical weapons, as well as illicit missile programmes. We studied a few outstanding questions regarding the Iraqi nuclear weapons programme that had been discovered and dismantled in the early 1990s; we looked for new evidence and investigated leads and suspicions passed on to us by national governments; we inspected many sites and interviewed Iraqi scientists and officials in person; and we analysed the data. By early 2003 we knew at a very high level of confidence that there was no nuclear weapons effort of any kind in Iraq, and we were regularly passing this information back to the UN Security Council. We were not wrong.”
“ChatGPT: Opportunities and Challenges for the Nuclear Agenda”
In this work published by the James Martin Center for Nonproliferation Studies, Yanliang Pan discusses the potential for misuse of ChatGPT in academia, politics, and cybersecurity, focusing on the nuclear agenda. He writes in part, “However, just as AI instruments can be used to advance the nuclear agenda, they also present risks that cannot be ignored. For instance, ChatGPT’s potential to enhance the capabilities of malign cyber actors represents a serious danger to nuclear security. With the digitalization of instrumentation and control systems, nuclear facilities are increasingly vulnerable to cyber threats, including malware and phishing attacks that ChatGPT is most proficient in assisting. Testing shows, for example, that the AI model has no qualms about writing fake emails to nuclear facility employees asking for access credentials – in different languages and styles of writing as requested…Indeed, it has no way of knowing whether the email is fake at all as it lacks the ability to check the user’s credentials. Upon the user’s request, the AI model will also identify common vulnerabilities in specific systems of a nuclear facility and list the malware that has been used in the past to target those systems…”
“Now AI Can Be Used to Design New Proteins”
In this piece for TheScientist, Dr. Kamal Nahas explains advancements in AI, writing “Artificial intelligence algorithms have had a meteoric impact on protein structure, such as when DeepMind’s AlphaFold2 predicted the structures of 200 million proteins. Now, David Baker and his team of biochemists at the University of Washington have taken protein-folding AI a step further. In a Nature publication from February 22, they outlined how they used AI to design tailor-made, functional proteins that they could synthesize and produce in live cells, creating new opportunities for protein engineering. Ali Madani, founder and CEO of Profluent, a company that uses other AI technology to design proteins, says this study “went the distance” in protein design and remarks that we’re now witnessing “the burgeoning of a new field.”
“Trust In US Federal, State, And Local Public Health Agencies During COVID-19: Responses And Policy Implications”
From Health Affairs: “Public health agencies’ ability to protect health in the wake of COVID-19 largely depends on public trust. In February 2022 we conducted a first-of-its-kind nationally representative survey of 4,208 US adults to learn the public’s reported reasons for trust in federal, state, and local public health agencies. Among respondents who expressed a “great deal” of trust, that trust was not related primarily to agencies’ ability to control the spread of COVID-19 but, rather, to beliefs that those agencies made clear, science-based recommendations and provided protective resources. Scientific expertise was a more commonly reported reason for “a great deal” of trust at the federal level, whereas perceptions of hard work, compassionate policy, and direct services were emphasized more at the state and local levels. Although trust in public health agencies was not especially high, few respondents indicated that they had no trust. Lower trust was related primarily to respondents’ beliefs that health recommendations were politically influenced and inconsistent. The least trusting respondents also endorsed concerns about private-sector influence and excessive restrictions and had low trust in government overall. Our findings suggest the need to support a robust federal, state, and local public health communications infrastructure; ensure agencies’ authority to make science-based recommendations; and develop strategies for engaging different segments of the public.”

Global BioLabs 2023 Launch- “High Consequence Bio Labs: Growing Risks and Lagging Governance”
“The Global Biolabs Initiative is proud to announce the launch of its new report, Global BioLabs 2023, and an updated interactive map of BSL4 and BSL3+ labs. With the global expansion of BSL4 and BSL3+ labs, gaps in biosecurity and biosafety governance are widening. Since its inception in 2021, the Global Biolabs Initiative has tracked the proliferation of the highest containment labs, identified several key trends in their construction and operation, developed biorisk management scorecards to measure how well countries are governing biosafety, biosecurity, and dual-use research, and mapped the global biorisk management architecture. The pace of BSL4/BSL3+ labs expansion is outpacing current biosafety and biosecurity regulations, and coordinated international action is needed to address increasing biorisks.”
“Dr Filippa Lentzos, King’s College London, and Dr Gregory Koblentz, George Mason University, will present the Global BioLabs 2023 report, describe key trends, and discuss recommendations for strengthening global biorisk management. The event will also feature a demonstration of the interactive map: globalbiolabs.org.”
This event will take place March 16, 2023, 1 pm GMT. Register for the Zoom webinar here and access Global Biolabs tools and resources at globalbiolabs.org.

Penetrate, Exploit, Disrupt, Destroy – with Dr. Craig J. Wiener
From the Alperovitch Institute: “Join us on Wednesday, March 15th at 5pm at the SAIS Hopkins Kenney Auditorium. Dr. Craig J. Wiener is recognized as an expert in major foreign adversary espionage, sabotage and strategic capabilities that pose threats to the U.S. Government (USG) and North Atlantic Treaty Organization. Dr. Wiener’s previous position was as the Senior Technical Analyst for the Department of Energy’s (DOE) Office of Intelligence and Counterintelligence where he fulfilled a role as DOE’s lead all source cyber threat analyst, the Department’s representative to the National Security Council for Cyber Operations, a key member of National Intelligence Council Special Analytic Groups, and a government briefer and/or advisor for Defense Science Board studies on Cyber as a Strategic Capability, Homeland Defense, Strategic Surprise and the future of US Military Superiority among other topics. Additionally, Dr. Wiener initiated and led studies for special nuclear weapons related threat and vulnerability analyses and advanced technical security threats to USG equities by foreign adversaries and engaged in the development, planning and operationalization of counter-adversary strategies across multiple domains of operations. Dr. Wiener joined the MITRE Corporation as a Technical Fellow in early-2020, where he supports key U.S. Government (USG) national security initiatives. He was recently appointed by the Secretary of Energy to the Electricity Advisory Committee to advise DOE on current and future electric grid reliability, resilience, security, sector interdependence, and policy issues.”
Dr. Wiener is an alumnus of the Biodefense PhD Program! Learn more and register for this event here.
Online Event: Discussion with Amb. van der Kwast About What to Expect at the 5th CWC Review Conference
“The Fifth Five-Year Review Conference (RC-5) for the 1997 Chemical Weapons Convention will be held in the Hague from May 15-19, 2023.”
“At the conference, member states and the broader chemical weapons disarmament community will gather to assess past achievements, treaty implementation, and compliance, and discuss plans to strengthen the CWC in the years ahead.”
“You are invited to join a virtual discussion with Ambassador Henk Cor van der Kwast, the chair-designate for the Review Conference, who will share his hopes and expectations for the conference’s outcomes.”
“Paul Walker, the Chair of the CWC Coalition, will moderate. Amb. van der Kwast’s remarks will be followed by a Q&A session.”
“This discussion will be on the record.”
“This special event will be open to all members of the CWC Coalition, and other interested members of the public, journalists, and diplomats.”
This webinar will take place on March 21 at 11 am EST. Register here.
Book Talk with Dr. Katherine Paris on “Genome Editing and Biological Weapons: Assessing the Risk of Misuse”
“Dr. Katherine Paris, an alumnus of the Mason Biodefense PhD program, recently released her new book “Genome Editing and Biological Weapons: Assessing the Risk of Misuse.” Join the NextGen Global Health Security Network for a conversation with Dr. Paris to learn about her research!” This event will take place on Wednesday, March 22, from 7-8 PM. Register for the Zoom here: https://cglink.me/2d7/r2064992

Intelligence Studies Consortium
“On March 24, 2023, the Intelligence Studies Consortium is convening its third symposium, entitled New Perspectives in Intelligence Studies. This year, George Mason’s Schar School of Policy and Government is hosting. The symposium will be from 8 AM to 4 PM in Rooms 125-126 Van Metre Hall, 3351 Fairfax Drive, Arlington, VA. The closest Metro is Virginia Square/GMU on the Orange and Silver lines.
The symposium will feature student presentations in four panels:
- Russia and China
- Violent Non-State Actors
- Emerging Technologies
- Transnational Challenges
There will be an 8:30 AM keynote address from the Assistant Secretary of the Treasury, Shannon Corless, and a lunchtime conversation with General Michael V. Hayden.
We encourage students to attend in person. We have also provided a livestream option for those not in the Washington DC area.”
Learn more and register here.

Weekly Trivia Question
You read the Pandora Report every week and now it’s time for you to show off what you know! The first person to send the correct answer to biodefense@gmu.edu will get a shout out in the following issue (first name last initial). Our question this week is: In 1978, Georgi Markov, a Bulgarian dissident, was poisoned with what agent?
Shout out to Scott H. for winning last week’s trivia! The correct answer to last week’s question, “This chemical agent features in Roald Dahl’s famous short story, The Landlady, in which the main character is given a tea that tastes of bitter almonds. What is the name of this agent?” is potassium cyanide.







 Love maps and diseases? Or do you simply like knowing what kinds of vectored diseases are transmitted around you? Check out the USGS disease maps that also allow you to interact with them. Utilizing data from CDC’s ArboNET, you can look at transmission among humans, mosquitoes, birds, sentinel animals, and veterinary transmission. The observable diseases include West Nile Virus, St. Louis Encephalitis, Eastern Equine Encephalitis, Western Equine Encephalitis, La Crosse Encephalitis, Powassan Virus, Dengue fever (locally acquired and imported), and Chikungunya (locally acquired and imported). The USGS disease maps allow us to not only have a better understanding of vectored disease transmission, but also landscape epidemiology.
Love maps and diseases? Or do you simply like knowing what kinds of vectored diseases are transmitted around you? Check out the USGS disease maps that also allow you to interact with them. Utilizing data from CDC’s ArboNET, you can look at transmission among humans, mosquitoes, birds, sentinel animals, and veterinary transmission. The observable diseases include West Nile Virus, St. Louis Encephalitis, Eastern Equine Encephalitis, Western Equine Encephalitis, La Crosse Encephalitis, Powassan Virus, Dengue fever (locally acquired and imported), and Chikungunya (locally acquired and imported). The USGS disease maps allow us to not only have a better understanding of vectored disease transmission, but also landscape epidemiology.
Happy Holidays from your friends at the Pandora Report and GMU Biodefense! If you’re starting a New Year’s resolutions list for things to improve, it sounds like you’ve got company – the
Happy Holidays from your friends at the Pandora Report and GMU Biodefense! If you’re starting a New Year’s resolutions list for things to improve, it sounds like you’ve got company – the  The Commandant’s Reading List
The Commandant’s Reading List 



